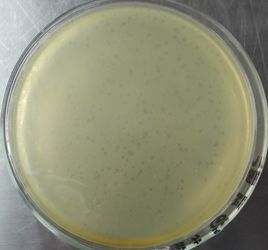
雙層平板法 雙層平板法

操作步驟
雙層瓊脂平板法融化下層培養基,倒平板(約10mL/皿)待用。
2 倒上層瓊脂
融化上層培養基,待融化的上層培養基冷卻至50℃左右時,每管中加入敏感指示菌 (大腸桿菌) 菌液0.2mL,待檢樣品液或上述噬菌體增殖液0.2~0.5mL,混合後立即倒入上層平板鋪平。
3 恆溫培養
30℃恆溫培養6~12h觀察結果。
4 觀察結果
如有噬菌體,則在雙層培養基的上層出現透亮無菌圓形空斑——噬菌斑
雙層平板法,又叫雙層瓊脂平板法,先在培養皿中倒入底層固體培養基,凝固後再倒入含有宿主細菌和一定稀釋度噬菌體的半固體培養基。培養一段時間後,計算噬菌斑的數量。
雙層瓊脂平板法平板太陽能集熱器吸熱板結構形式在平板形狀的吸熱板上,通常都布置有排管和集管。 平板太陽能集熱器吸熱板材料一般採用平板太陽能集熱器翼管式吸熱板鋁合金。 平...
百科名片 工作原理 基本結構 特點壁式採煤法回採工作面長度較長;工作面兩端有可供運輸、通風和行人的巷道;回採工作面向前推進時,必須不斷支護;採空區要隨工作面推進按一定方法及時處理;回採工...
壁式採煤法 正文 配圖 相關連線比擬法是實驗應力分析方法的一種。它是根據兩種物理現象之間的比擬關係,通過一種物理現象的觀測試驗,研究另一種物理現象的方法。在實驗應力分析領域中,常用的有...
比擬法 正文 配圖 相關連線單菌落瓊脂塊法篩選抗生素高產菌主要是依據將誘變後產生的單菌落在早期用打孔器將其瓊脂小塊取出,結合抑菌圈的方法,快速鑑定,提高篩選效率。這種突變引起的任何...
[7]高等擔子菌的分離(7)土壤中真菌的檢測和分離[1]稀釋平板法[2...純化法(2)稀釋純化法(3)瓊膠平板表面單孢子挑取法(4)玻璃毛細管...程度1.記載方法(1)直接計數法(2)分級計數法[1] 分級用文字敘述[2...
內容介紹 作品目錄一直不鼓勵發展,而PVC來源也非常多,其中有電石法生產的和石油法生產...使用更好的石油法生產,質量當然更加有保障。而使用塑膠代替金屬是社會...效果更好的鋁塑共擠門窗。種類雙層真空雙層真空玻璃和雙層中空玻璃在結構和...
簡介 種類 組合形式 效果評定 環境區分:生態學(一級學科);污染生態學(二級學科)定義3:圍繞細胞或細胞器的脂雙層膜,由磷脂雙層結合有蛋白質和膽固醇、糖脂構成,起滲透屏障、物質轉運和...)定義4:圍繞細胞或細胞器的脂雙層膜。由磷脂雙層結合有蛋白質和膽固醇...
科技名詞定義 運輸功能 特性 結構 結構模型原性噬菌體的溶原性細胞經紫外線誘導而裂解出來,在攤布有敏感菌株的瓊脂平板...,同一噬菌體所形成的噬菌斑形狀大小基本一致。不同稀釋度的噬菌體裂解液在雙層瓊脂平板培養基上所形成的噬菌斑的數目不同,通過計算噬菌斑數目可測定噬菌體...
相關資料 參考資料